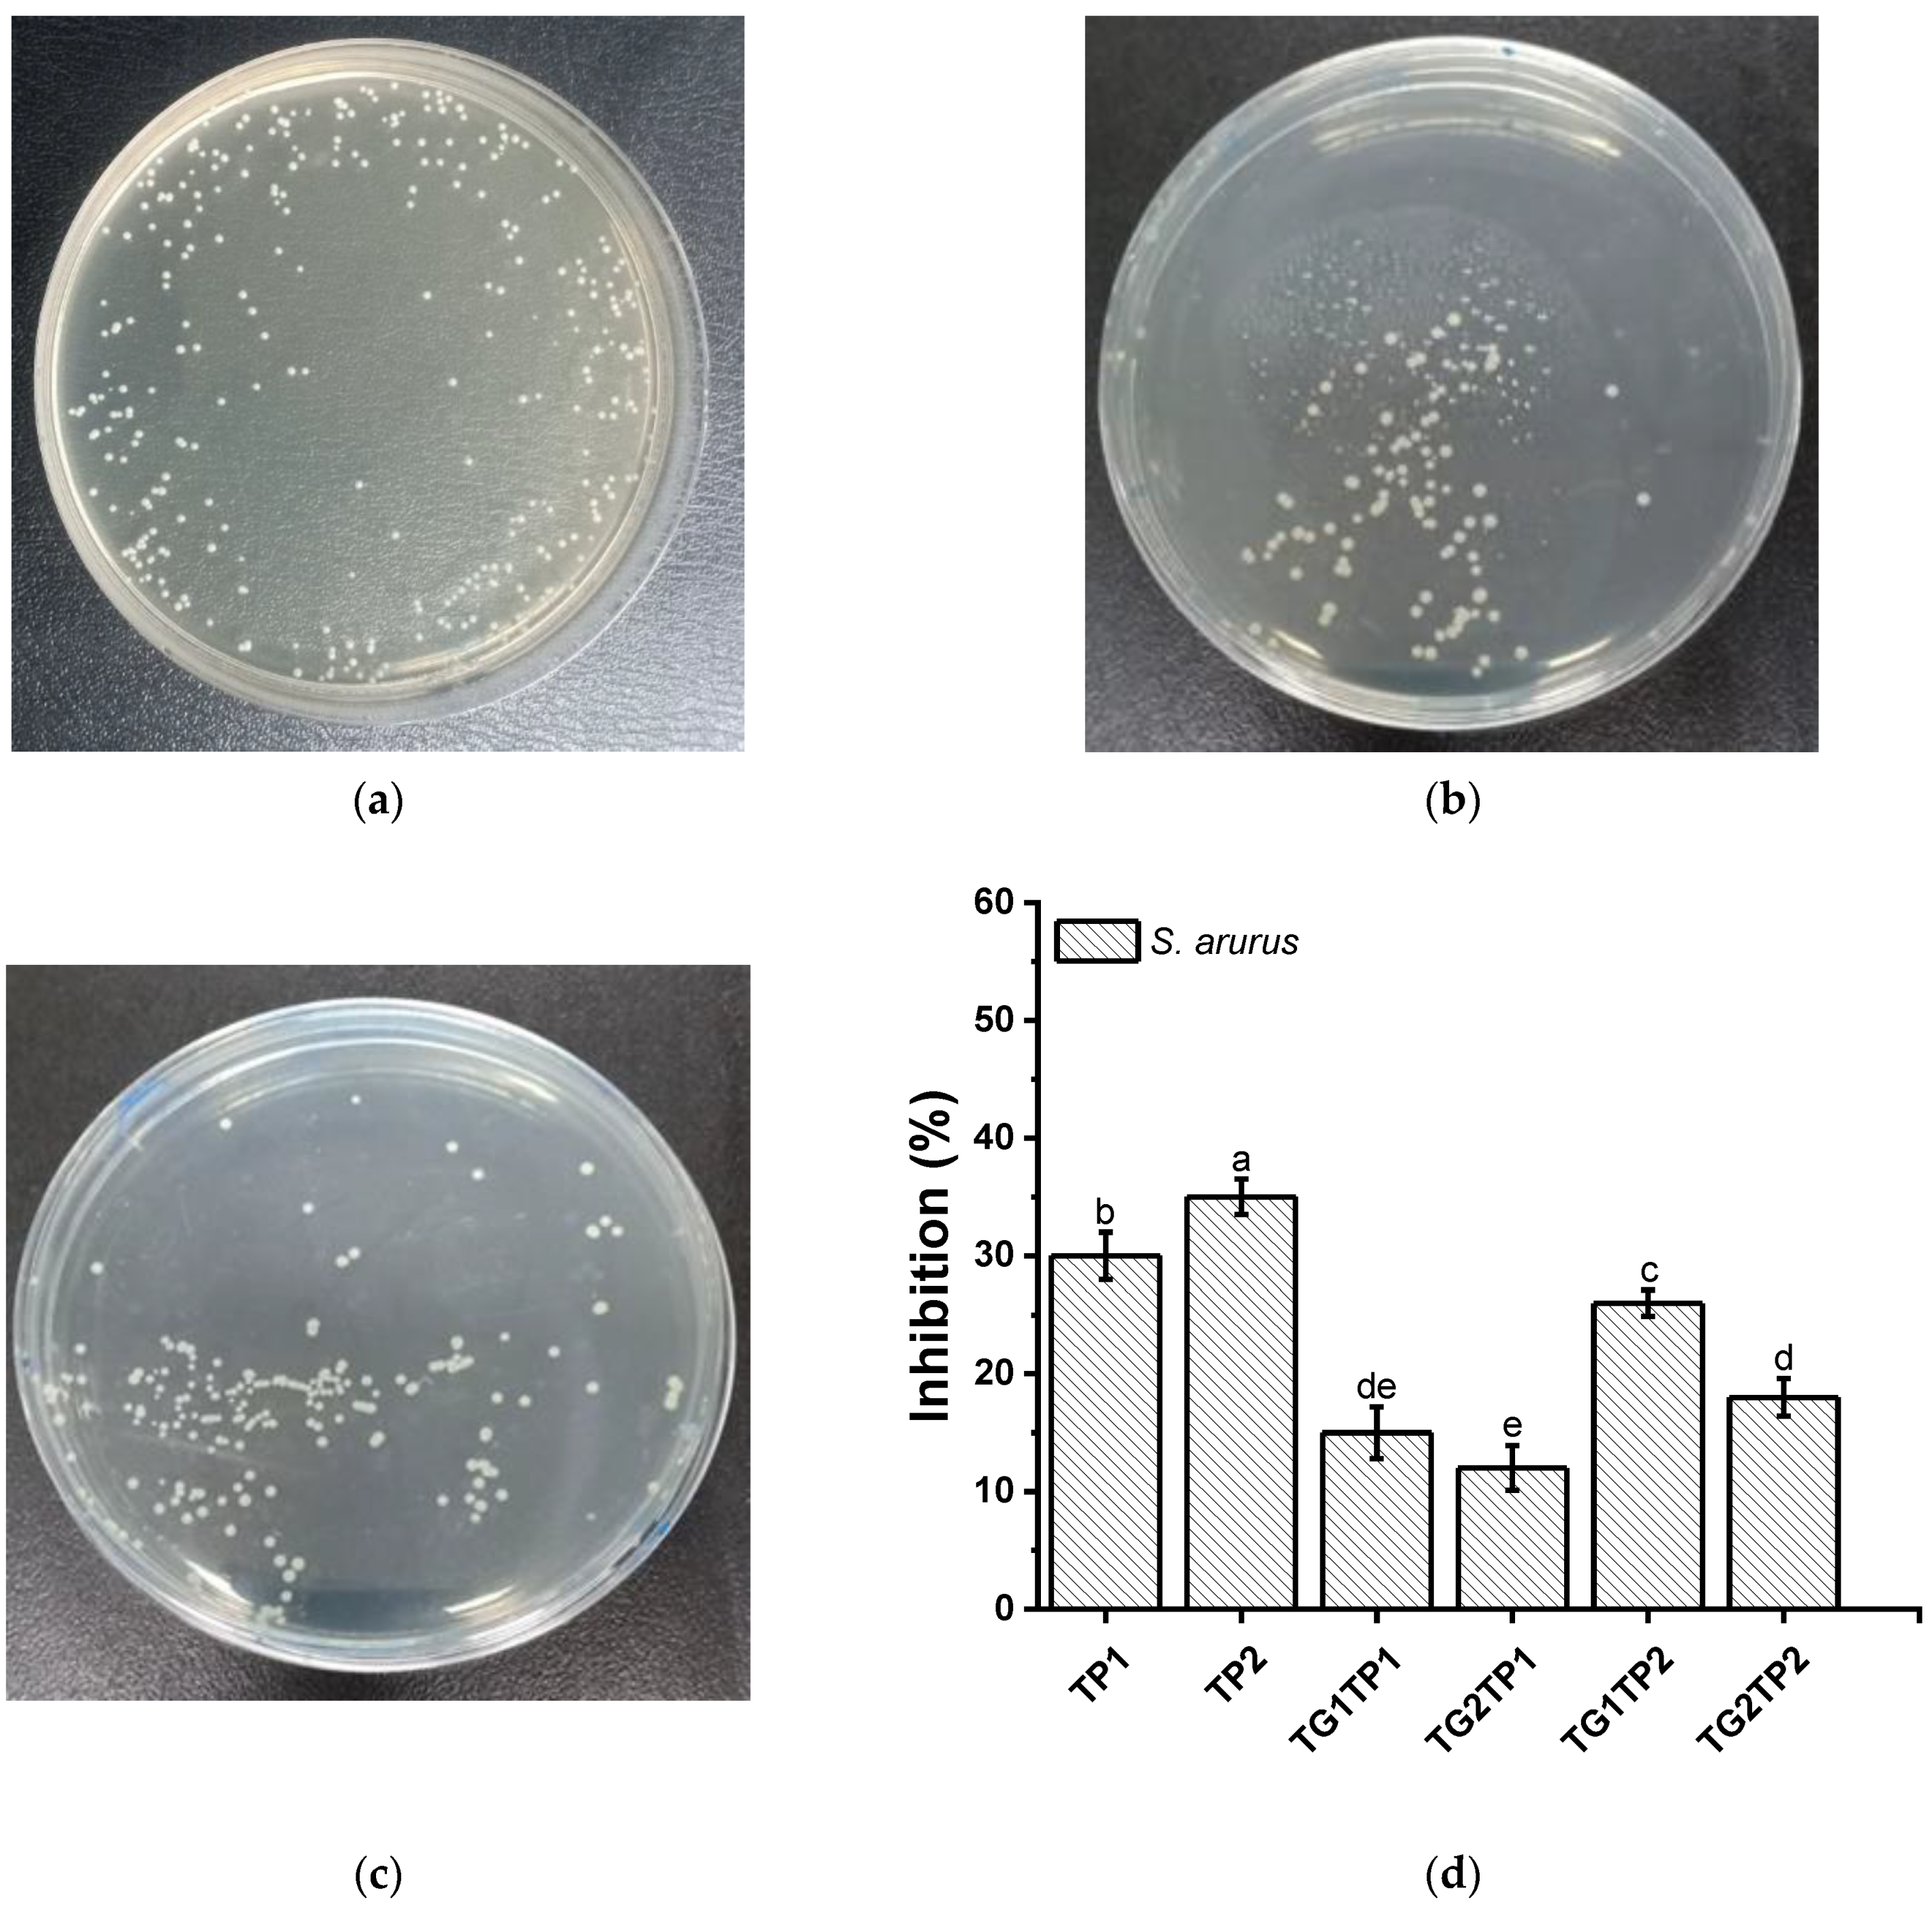
Polymers 15 02882 g007a Polymers 15 02882 g007a

Encapsulation of Tea Polyphenol in Zein through Complex Coacervation Technique to Control the Release of the Phenolic Compound from Gelatin–Zein Composite Film
Abstract
1. Introduction
2. Materials and Methods
2.1. Materials
2.2. Preparation of TP-Loaded Zein Microparticles and Film
2.3. Retention of TP
2.4. One-Way Release Measurement
2.5. Antioxidant Activity
2.6. Crosslinking Degree and SDS-PAGE
2.7. Physical, Structural, and Mechanical Characterization
2.8. Color and Transparency
2.9. Antimicrobial Properties
2.10. Statistical Analysis
3. Results and Discussions
3.1. Retentivity and Release of TP from the Film
3.2. Antioxidant Activity
3.3. Crosslinking Degree
3.4. Physical Properties of the Films
3.5. Thermal Properties
3.6. Film’s Structure
3.6.1. Secondary Structure
3.6.2. Microstructure
3.6.3. Optical Properties
3.7. Antibacterial Property
4. Conclusions
Supplementary Materials
Author Contributions
Funding
Institutional Review Board Statement
Data Availability Statement
Acknowledgments
Conflicts of Interest
References
- Cristina Ferrer Carneiro, H.; Hoster, K.; Reineccius, G.; Silvia Prata, A. Flavoring properties that affect the retention of volatile components during encapsulation process. Food Chem. X 2022, 13, 100230. [Google Scholar] [CrossRef]
- Vergara, L.P.; dos Santos Hackbart, H.C.; Jansen Alves, C.; Reissig, G.N.; Wachholz, B.S.; Borges, C.D.; Chim, J.F.; Zambiazi, R.C. Encapsulation of phenolic compounds through the complex coacervation technique for the enrichment of diet chewable candies. Food Biosci. 2023, 51, 102256. [Google Scholar] [CrossRef]
- Veneranda, M.; Hu, Q.; Wang, T.; Luo, Y.; Castro, K.; Madariaga, J.M. Formation and characterization of zein-caseinate-pectin complex nanoparticles for encapsulation of eugenol. LWT 2018, 89, 596–603. [Google Scholar] [CrossRef]
- Ahsan, S.M.; Rao, C.M. The role of surface charge in the desolvation process of gelatin: Implications in nanoparticle synthesis and modulation of drug release. Int. J. Nanomed. 2017, 12, 795–808. [Google Scholar] [CrossRef]
- Niaz, T.; Shabbir, S.; Noor, T.; Imran, M. Active Composite Packaging Reinforced with Nisin-Loaded Nano-Vesicles for Extended Shelf Life of Chicken Breast Filets and Cheese Slices. Food Bioprocess Technol. 2022, 15, 1284–1298. [Google Scholar] [CrossRef]
- Remucal, C.K.; Salhi, E.; Walpen, N.; von Gunten, U. Molecular-Level Transformation of Dissolved Organic Matter during Oxidation by Ozone and Hydroxyl Radical. Environ. Sci. Technol. 2020, 54, 10351–10360. [Google Scholar] [CrossRef]
- Fang, Z.; Zhao, Y.; Warner, R.D.; Johnson, S.K. Active and intelligent packaging in meat industry. Trends Food Sci. Technol. 2017, 61, 60–71. [Google Scholar] [CrossRef]
- Yan, Z.; Zhong, Y.; Duan, Y.; Chen, Q.; Li, F. Antioxidant mechanism of tea polyphenols and its impact on health benefits. Anim. Nutr. 2020, 6, 115–123. [Google Scholar] [CrossRef]
- Dou, L.; Li, B.; Zhang, K.; Chu, X.; Hou, H. Physical properties and antioxidant activity of gelatin-sodium alginate edible films with tea polyphenols. Int. J. Biol. Macromol. 2018, 118, 1377–1383. [Google Scholar] [CrossRef]
- Nie, X.; Wang, L.; Wang, Q.; Lei, J.; Hong, W.; Huang, B.; Zhang, C. Effect of a Sodium Alginate Coating Infused with Tea Polyphenols on the Quality of Fresh Japanese Sea Bass (Lateolabrax japonicas) Fillets. J. Food Sci. 2018, 83, 1695–1700. [Google Scholar] [CrossRef]
- Wang, X.; Huang, X.; Zhang, F.; Hou, F.; Yi, F.; Sun, X.; Yang, Q.; Han, X.; Liu, Z. Characterization of chitosan/zein composite film combined with tea polyphenol and its application on postharvest quality improvement of mushroom (Lyophyllum decastes Sing.). Food Packag. Shelf Life 2022, 33, 100869. [Google Scholar] [CrossRef]
- Qin, Y.-Y.; Yang, J.-Y.; Lu, H.-B.; Wang, S.-S.; Yang, J.; Yang, X.-C.; Chai, M.; Li, L.; Cao, J.-X. Effect of chitosan film incorporated with tea polyphenol on quality and shelf life of pork meat patties. Int. J. Biol. Macromol. 2013, 61, 312–316. [Google Scholar] [CrossRef]
- Tsao, R. 13—Synergistic interactions between antioxidants used in food preservation. In Handbook of Antioxidants for Food Preservation; Shahidi, F., Ed.; Woodhead Publishing: Cambridge, UK, 2015; pp. 335–347. [Google Scholar] [CrossRef]
- Al-Hassan, A.A.; Norziah, M.H. Effect of transglutaminase induced crosslinking on the properties of starch/gelatin films. Food Packag. Shelf Life 2017, 13, 15–19. [Google Scholar] [CrossRef]
- Ahammed, S.; Liu, F.; Wu, J.; Khin, M.N.; Yokoyama, W.H.; Zhong, F. Effect of transglutaminase crosslinking on solubility property and mechanical strength of gelatin-zein composite films. Food Hydrocoll. 2021, 116, 106649. [Google Scholar] [CrossRef]
- Topuz, F.; Uyar, T. Antioxidant, antibacterial and antifungal electrospun nanofibers for food packaging applications. Food Res. Int. 2020, 130, 108927. [Google Scholar] [CrossRef]
- Chen, X.; Xiao, J.; Cai, J.; Liu, H. Phase separation behavior in zein-gelatin composite film and its modulation effects on retention and release of multiple bioactive compounds. Food Hydrocoll. 2020, 109, 106105. [Google Scholar] [CrossRef]
- Kuai, L.; Liu, F.; Chiou, B.-S.; Avena-Bustillos, R.J.; McHugh, T.H.; Zhong, F. Controlled release of antioxidants from active food packaging: A review. Food Hydrocoll. 2021, 120, 106992. [Google Scholar] [CrossRef]
- Alnadari, F.; Bassey, A.P.; Abdin, M.; Salama, M.A.; Nasiru, M.M.; Dai, Z.; Hu, Y.; Zeng, X. Development of Hybrid Film Based on Carboxymethyl Chitosan-Gum Arabic Incorporated Citric Acid and Polyphenols from Cinnamomum camphora Seeds for Active Food Packaging. J. Polym. Environ. 2022, 30, 3582–3597. [Google Scholar] [CrossRef]
- Zheng, H.; Zhao, M.; Dong, Q.; Fan, M.; Wang, L.; Li, L. Extruded transglutaminase-modified gelatin–beeswax composite packaging film. Food Hydrocoll. 2022, 132, 107849. [Google Scholar] [CrossRef]
- Wu, J.; Zhong, F.; Li, Y.; Shoemaker, C.F.; Xia, W. Preparation and characterization of pullulan–chitosan and pullulan–carboxymethyl chitosan blended films. Food Hydrocoll. 2013, 30, 82–91. [Google Scholar] [CrossRef]
- Kelkawi, A.H.A.; Hashemzadeh, H.; Pashandi, Z.; Tiraihi, T.; Naderi-Manesh, H. Differentiation of PC12 cell line into neuron by Valproic acid encapsulated in the stabilized core-shell liposome-chitosan Nano carriers. Int. J. Biol. Macromol. 2022, 210, 252–260. [Google Scholar] [CrossRef]
- Han, Y.; Yu, M.; Wang, L. Preparation and characterization of antioxidant soy protein isolate films incorporating licorice residue extract. Food Hydrocoll. 2018, 75, 13–21. [Google Scholar] [CrossRef]
- Qi, C.; Liu, G.; Ping, Y.; Yang, K.; Tan, Q.; Zhang, Y.; Chen, G.; Huang, X.; Xu, D. A comprehensive review of nano-delivery system for tea polyphenols: Construction, applications, and challenges. Food Chem. X 2023, 17, 100571. [Google Scholar] [CrossRef]
- Xia, C.; Wang, W.; Wang, L.; Liu, H.; Xiao, J. Multilayer zein/gelatin films with tunable water barrier property and prolonged antioxidant activity. Food Packag. Shelf Life 2019, 19, 76–85. [Google Scholar] [CrossRef]
- Roy, S.; Rhim, J.-W. Preparation of antimicrobial and antioxidant gelatin/curcumin composite films for active food packaging application. Colloids Surf. B Biointerfaces 2020, 188, 110761. [Google Scholar] [CrossRef]
- Mao, L.; Ma, L.; Fu, Y.; Chen, H.; Dai, H.; Zhu, H.; Wang, H.; Yu, Y.; Zhang, Y. Transglutaminase modified type A gelatin gel: The influence of intra-molecular and inter-molecular cross-linking on structure-properties. Food Chem. 2022, 395, 133578. [Google Scholar] [CrossRef]
- Fernandez-Bats, I.; Di Pierro, P.; Villalonga-Santana, R.; Garcia-Almendarez, B.; Porta, R. Bioactive mesoporous silica nanocomposite films obtained from native and transglutaminase-crosslinked bitter vetch proteins. Food Hydrocoll. 2018, 82, 106–115. [Google Scholar] [CrossRef]
- Wu, H.; Lei, Y.; Zhu, R.; Zhao, M.; Lu, J.; Xiao, D.; Jiao, C.; Zhang, Z.; Shen, G.; Li, S. Preparation and characterization of bioactive edible packaging films based on pomelo peel flours incorporating tea polyphenol. Food Hydrocoll. 2019, 90, 41–49. [Google Scholar] [CrossRef]
- Uranga, J.; Puertas, A.I.; Etxabide, A.; Dueñas, M.T.; Guerrero, P.; de la Caba, K. Citric acid-incorporated fish gelatin/chitosan composite films. Food Hydrocoll. 2019, 86, 95–103. [Google Scholar] [CrossRef]
- Risyon, N.P.; Othman, S.H.; Basha, R.K.; Talib, R.A. Characterization of polylactic acid/halloysite nanotubes bionanocomposite films for food packaging. Food Packag. Shelf Life 2020, 23, 100450. [Google Scholar] [CrossRef]
- Wang, Y.; Liu, A.; Ye, R.; Wang, W.; Li, X. Transglutaminase-induced crosslinking of gelatin–calcium carbonate composite films. Food Chem. 2015, 166, 414–422. [Google Scholar] [CrossRef] [PubMed]
- Chambi, H.; Grosso, C. Edible films produced with gelatin and casein cross-linked with transglutaminase. Food Res. Int. 2006, 39, 458–466. [Google Scholar] [CrossRef]
- Fan, H.Y.; Duquette, D.; Dumont, M.-J.; Simpson, B.K. Salmon skin gelatin-corn zein composite films produced via crosslinking with glutaraldehyde: Optimization using response surface methodology and characterization. Int. J. Biol. Macromol. 2018, 120, 263–273. [Google Scholar] [CrossRef]
- Liu, F.; Antoniou, J.; Li, Y.; Yi, J.; Yokoyama, W.; Ma, J.; Zhong, F. Preparation of Gelatin Films Incorporated with Tea Polyphenol Nanoparticles for Enhancing Controlled-Release Antioxidant Properties. J. Agric. Food Chem. 2015, 63, 3987–3995. [Google Scholar] [CrossRef]
- Zhang, Q.; Zhang, J.; Zhang, J.; Xu, D.; Li, Y.; Liu, Y.; Zhang, X.; Zhang, R.; Wu, Z.; Weng, P. Antimicrobial Effect of Tea Polyphenols against Foodborne Pathogens: A Review. J. Food Prot. 2021, 84, 1801–1808. [Google Scholar] [CrossRef]
- Kanatt, S.R.; Rao, M.S.; Chawla, S.P.; Sharma, A. Effects of chitosan coating on shelf-life of ready-to-cook meat products during chilled storage. LWT—Food Sci. Technol. 2013, 53, 321–326. [Google Scholar] [CrossRef]
- Zhong, Y.; Song, X.; Li, Y. Antimicrobial, physical and mechanical properties of kudzu starch–chitosan composite films as a function of acid solvent types. Carbohydr. Polym. 2011, 84, 335–342. [Google Scholar] [CrossRef]
- Leite, L.S.F.; Bilatto, S.; Paschoalin, R.T.; Soares, A.C.; Moreira, F.K.V.; Oliveira, O.N.; Mattoso, L.H.C.; Bras, J. Eco-friendly gelatin films with rosin-grafted cellulose nanocrystals for antimicrobial packaging. Int. J. Biol. Macromol. 2020, 165, 2974–2983. [Google Scholar] [CrossRef]

| Sample | Release Property | Crosslinking Degree | Mechanical Property | |||
|---|---|---|---|---|---|---|
| D × 10−11 | R2 | Tensile Strength | Elongation at Break | Thickness | ||
| (cm2/s) | (%) | (MPa) | (%) | (mm) | ||
| control | 108.7 ± 5.9 a | 9.5 ± 1.9 ab | 0.05 ± 0.003 a | |||
| TP1 | 1.2 | 0.963 | 97.6 ± 10.5 ab | 7.9 ± 1.7 ab | 0.07 ± 0.01 a | |
| TP2 | 1.2 | 0.931 | 90.9 ± 8.1 bc | 8.1 ± 2.3 ab | 0.06 ± 0.004 a | |
| TG1TP1 | 0.5 | 0.953 | 60.46 ± 4.96 ab | 100.6 ± 10.2 ab | 6.2 ± 0.6 b | 0.06 ± 0.002 a |
| TG2TP1 | 0.5 | 0.930 | 62.74 ± 1.51 ab | 102.5 ± 4.8 ab | 5.5 ± 1.2 b | 0.06 ± 0.013 a |
| TG1TP2 | 0.6 | 0.963 | 54.95 ± 6.59 b | 101.3 ± 7.1 ab | 7.5 ± 1.8 ab | 0.06 ± 0.009 a |
| TG2TP2 | 0.5 | 0.922 | 59.05 ± 1.54 ab | 86.5 ± 5.3 bc | 10.4 ± 3.3 a | 0.06 ± 0.005 a |
| Films | Color | Light Transmittance (%) | Transparency Values | |||
|---|---|---|---|---|---|---|
| L* | a* | b* | ΔE* | 600 | ||
| control | 91.86 ± 0.07 b | −1.25 ± 0.01 g | 3.73 ± 0.25 f | 3.30 ± 0.05 g | 70.42 ± 1.64 c | 2.71 ± 0.18 ab |
| TG1 | 92.03 ± 0.07 b | −1.24 ± 0.01 g | 3.45 ± 0.40 g | 2.98 ± 0.10 h | 75.39 ± 0.36 a | 1.95 ± 0.03 f |
| TG2 | 92.28 ± 0.08 a | −1.26 ± 0.01 h | 3.31 ± 0.31 h | 2.76 ± 0.03 i | 73.11 ± 0.29 b | 2.03 ± 0.03 ef |
| TP1 | 91.27 ± 0.06 c | −0.97 ± 0.02 d | 4.24 ± 0.35 e | 4.00 ± 0.06 f | 69.44 ± 0.24 c | 2.21 ± 0.02 de |
| TP2 | 90.80 ± 0.07 d | −0.76 ± 0.02 a | 5.16 ± 0.32 c | 5.04 ± 0.06 c | 70.14 ± 0.28 c | 2.36 ± 0.03 cd |
| TG1TP1 | 91.45 ± 0.07 c | −0.99 ± 0.01 e | 4.43 ± 0.45 d | 4.09 ± 0.13 e | 68.65 ± 0.50 c | 2.63 ± 0.05 b |
| TG2TP1 | 91.28 ± 0.05 c | −0.87 ± 0.01 c | 4.45 ± 0.25 d | 4.19 ± 0.07 d | 69.13 ± 0.66 c | 2.51 ± 0.07 bc |
| TG1TP2 | 91.03 ± 0.06 d | −1.03 ± 0.02 f | 5.44 ± 0.29 b | 5.19 ± 0.03 b | 66.12 ± 0.78 d | 2.89 ± 0.08 a |
| TG2TP2 | 90.67 ± 0.06 d | −0.84 ± 0.01 b | 5.54 ± 0.31 a | 5.43 ± 0.03 a | 68.55 ± 1.10 c | 2.36 ± 0.10 cd |
Disclaimer/Publisher’s Note: The statements, opinions and data contained in all publications are solely those of the individual author(s) and contributor(s) and not of MDPI and/or the editor(s). MDPI and/or the editor(s) disclaim responsibility for any injury to people or property resulting from any ideas, methods, instructions or products referred to in the content. |
© 2023 by the authors. Licensee MDPI, Basel, Switzerland. This article is an open access article distributed under the terms and conditions of the Creative Commons Attribution (CC BY) license (https://creativecommons.org/licenses/by/4.0/).
Share and Cite
Ahammed, S.; Easdani, M.; Liu, F.; Zhong, F. Encapsulation of Tea Polyphenol in Zein through Complex Coacervation Technique to Control the Release of the Phenolic Compound from Gelatin–Zein Composite Film. Polymers 2023, 15, 2882. https://doi.org/10.3390/polym15132882
Ahammed S, Easdani M, Liu F, Zhong F. Encapsulation of Tea Polyphenol in Zein through Complex Coacervation Technique to Control the Release of the Phenolic Compound from Gelatin–Zein Composite Film. Polymers. 2023; 15(13):2882. https://doi.org/10.3390/polym15132882
Chicago/Turabian StyleAhammed, Shabbir, Md Easdani, Fei Liu, and Fang Zhong. 2023. "Encapsulation of Tea Polyphenol in Zein through Complex Coacervation Technique to Control the Release of the Phenolic Compound from Gelatin–Zein Composite Film" Polymers 15, no. 13: 2882. https://doi.org/10.3390/polym15132882
APA StyleAhammed, S., Easdani, M., Liu, F., & Zhong, F. (2023). Encapsulation of Tea Polyphenol in Zein through Complex Coacervation Technique to Control the Release of the Phenolic Compound from Gelatin–Zein Composite Film. Polymers, 15(13), 2882. https://doi.org/10.3390/polym15132882

